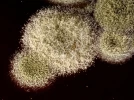
Moisissures, levures et autres micro-champignons

Un détail glissé dans la terre en hiver, et vos plantes échappent aux moisissures : la plupart des jardiniers l'ignorent
L’hiver approche, les plantes d’intérieur semblent au repos… mais un danger silencieux rôde : l’humidité stagnante. Elle favorise l’apparition de moisissures, souvent fatales pour vos pots. Pourtant, un objet très simple, glissé dans la terre, peut tout changer. Et il est déjà chez vous.

L’hiver, piège humide pour les plantes d’intérieur : pourquoi vos pots deviennent hostiles
Quand les températures chutent, l’évaporation ralentit, l’air se sature et l’humidité reste piégée dans la terre des pots. Loin d’être anodin, ce phénomène perturbe la respiration des racines jusqu’à provoquer leur pourrissement.
Dans les coins peu ventilés, près des fenêtres ou des radiateurs, les moisissures apparaissent : taches blanches, duvet grisâtre, odeurs de terre fermentée. Elles affaiblissent les plantes, bloquent leur croissance, voire les condamnent si rien n’est fait. D’où l’importance de prévenir dès les premiers signes d’humidité excessive.
Le bouchon en liège : ce petit geste qui protège naturellement la base des plantes
La solution est simple et accessible : un bouchon en liège peut devenir un véritable rempart naturel. Léger, absorbant et naturellement anti-moisissure, il agit comme un tampon au fond du pot. Sa structure poreuse capte l’eau en excès, limite la stagnation et améliore le drainage.
Le liège possède également des propriétés antifongiques naturelles. Il devient ainsi un allié discret mais efficace en hiver, lorsque l’air froid empêche le séchage rapide des substrats. C’est en plus une solution écologique et gratuite, déjà présente dans de nombreux foyers.
Comment bien utiliser le bouchon en liège pour prévenir les moisissures hivernales
Avant l’arrosage ou le rempotage hivernal, insérez un bouchon propre au fond du pot, sur la couche de drainage. Pour les petits pots, il est conseillé de le couper en deux afin de ne pas gêner les racines. L’objectif est d’absorber l’excès d’eau sans étouffer la plante.
Pour maximiser son efficacité :
-
Coupez les bouchons afin d’augmenter la surface d’absorption.
-
Remuez légèrement la terre en surface chaque semaine pour aérer.
-
Utilisez plusieurs bouchons dans les pots de grand diamètre.
-
Retirez-les au printemps, laissez-les sécher puis réutilisez-les.
Ce geste simple s’intègre facilement à une routine d’entretien hivernale, avec un bénéfice durable pour toutes les plantes d’intérieur.
Un effet bonus : drainage, microfaune et recyclage au jardin
Une fois utilisé, le bouchon en liège ne perd pas son intérêt. Broyé grossièrement, il peut être ajouté au compost ou utilisé comme paillage pour les jeunes semis. Autre astuce : en disposer autour des fraisiers ou des herbes aromatiques pour limiter la présence des escargots.
En plus de lutter contre l’humidité, le liège aère la terre, stimule la microfaune et favorise un sol vivant, même en saison froide. Un recyclage malin, sans gaspillage, parfaitement aligné avec les pratiques de jardinage écologique.
Ce qu’il faut retenir pour des plantes d’intérieur saines tout l’hiver
L’hiver impose une vigilance particulière. Chauffage, manque d’aération et arrosages inadaptés créent un terrain idéal pour les moisissures. En ajoutant un simple bouchon en liège dans les pots, ce risque diminue fortement.
-
Réduire l’arrosage dès que les températures baissent.
-
Aérer régulièrement les pièces, même par temps froid.
-
Glisser un bouchon propre dans chaque pot pour le drainage et l’absorption.
-
Utiliser des pots percés afin d’éviter l’eau stagnante.
Un petit geste, invisible mais précieux, qui protège les plantes tout l’hiver. Au printemps, elles repartiront plus vigoureuses, prêtes à fleurir pleinement.

Vos commentaires